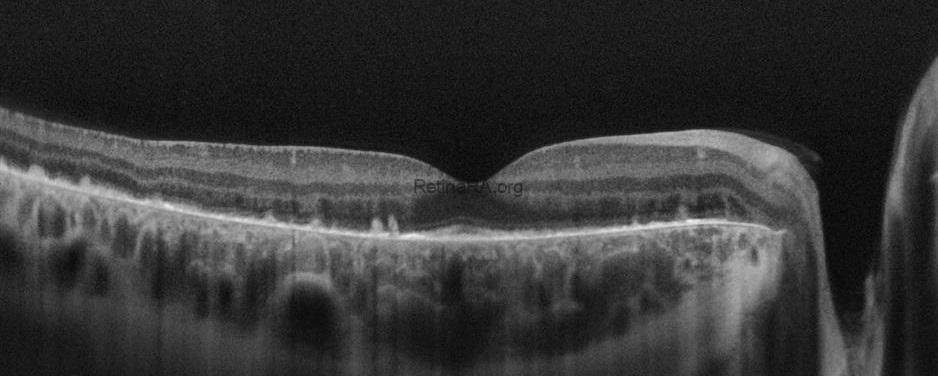
aydogdu_binnur__CZMI1799161423_20090101_Female_HD-1-Line-100x_20211123161542_OD_20230105161410
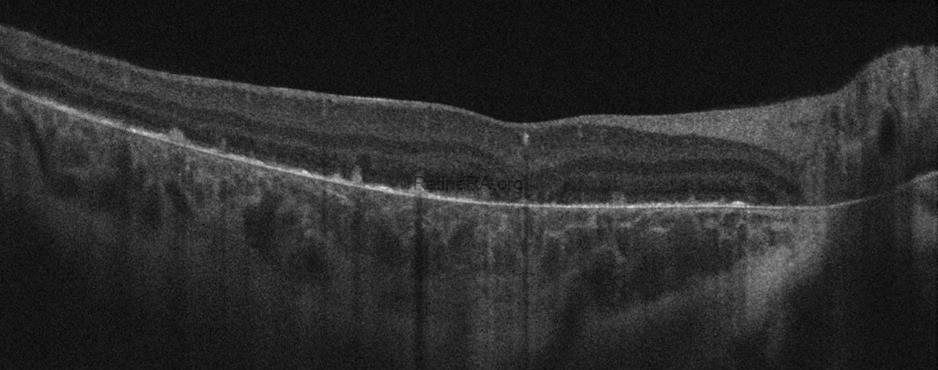
aydogdu_binnur__CZMI1799161423_20090101_Female_HD-21-Line_20211123161700_OD_20230105161250DN6weqX
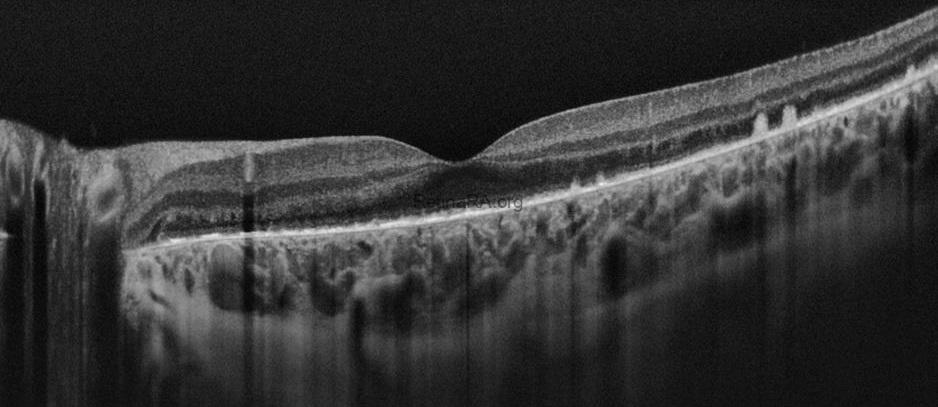
aydogdu_binnur__CZMI1799161423_20090101_Female_HD-1-Line-100x_20211123161751_OS_202301051614229cgrfD0
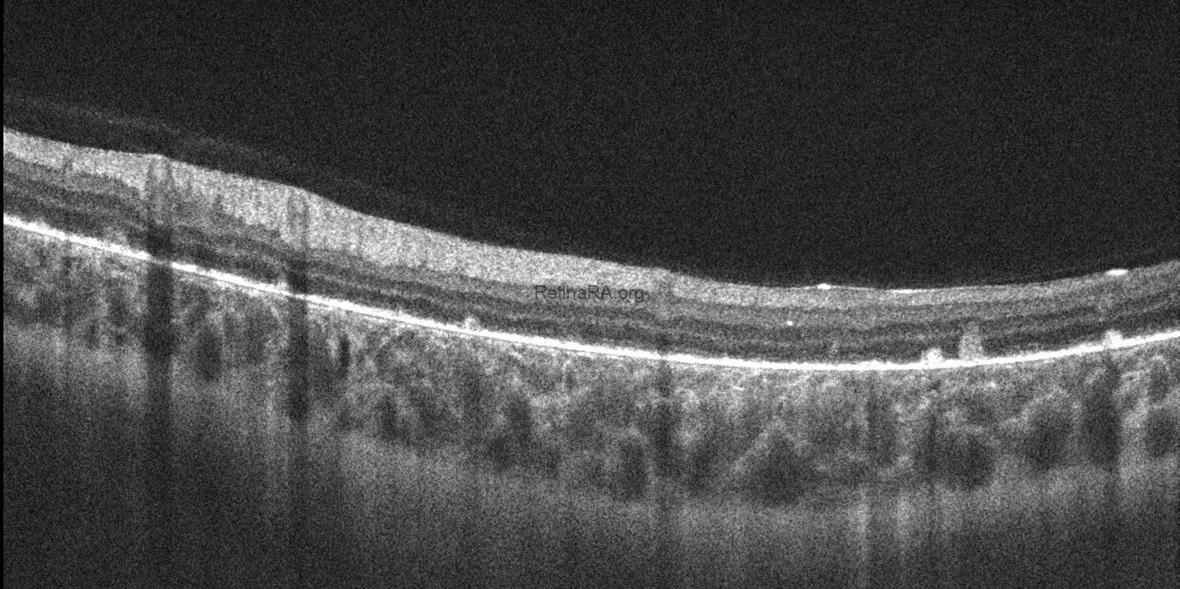
aydogdu_binnur__CZMI1799161423_20090101_Female_HD-21-Line_20211123162011_OS_202301051334019NCWWzX

A 12-year-old girl with a relative history of hereditary retinal dystrophy. Her family had recently noticed that her night vision had decreased. BCVA was 20/25 in the right eye and 20/25 in the left eye. No crystalline deposits were seen in the patient’s cornea. In most cases of Bietti crystalline dystrophy, crystalline deposits are found in the cornea, but in the early stages these deposits may not yet have formed. Color fundus photography showed scattered bright yellow-white retinal crystalline deposits in the posterior pole of the retina in both eyes. In early-stage Bietti crystalline dystrophy, crystalline deposits are more clearly seen in the retina. In contrast, the number of crystalline deposits gradually decreases in the following years as the severity of the disease increases.
Color fundus photography of early-stage Bietti Crystalline Dystrophy


Fundus autofluorescence imaging of early-stage Bietti Crystalline Dystrophy
Fundus autofluorescence imaging (FAF) also showed bilateral hyper-autofluorescent deposits surrounded by hypoautofluorescence lesions in the posterior pole.


Optical coherence tomography (OCT) imaging showed bilateral hyperreflective dots in the inner retinal layers, bright reflective deposits in the RPE-Bruch membrane complex, and the absence of outer retinal tubulations. Among degenerative retinal diseases, the frequency of outer retinal tubulations is highest in Bietti crystalline dystrophy. However, retinal atrophy must be evident for outer retinal tubulations to appear. Therefore, this finding may not be seen in early-stage disease. The ellipsoid zone, interdigitation zone, and RPE disruption were more prominent on parafoveal OCT scans. The presence of prominent crystalline retinal deposits, together with the FAF and OCT findings, led to the diagnosis of early-stage Bietti crystalline dystrophy in this patient.
OCT of early-stage Bietti Crystalline Dystrophy

Credit: M. Giray Ersoz, MD, FEBO
Biruni University School of Medicine, Department of Ophthalmology, Istanbul, Turkey
Instagram accounts: @retina.review and @retina.dr.girayersoz

